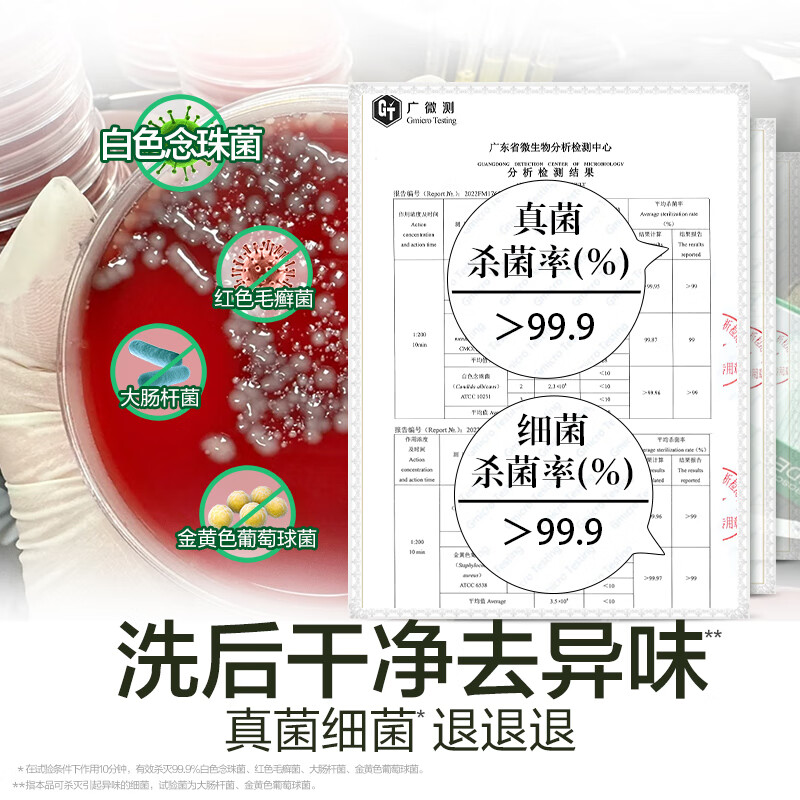
商品图片 2

滴露(Dettol)衣物内衣除菌液750ml99.9%灭真菌内裤消毒儿童适用可配内衣洗衣液
预估到手价 ¥50
原价: ¥50
历史券后价 ¥50
Dettol滴露京东自营旗舰店
店铺评分: 0
累计评价: 200000+
优惠券
商品标签
自营
plus
秒杀
7天无理由退货
商品详情